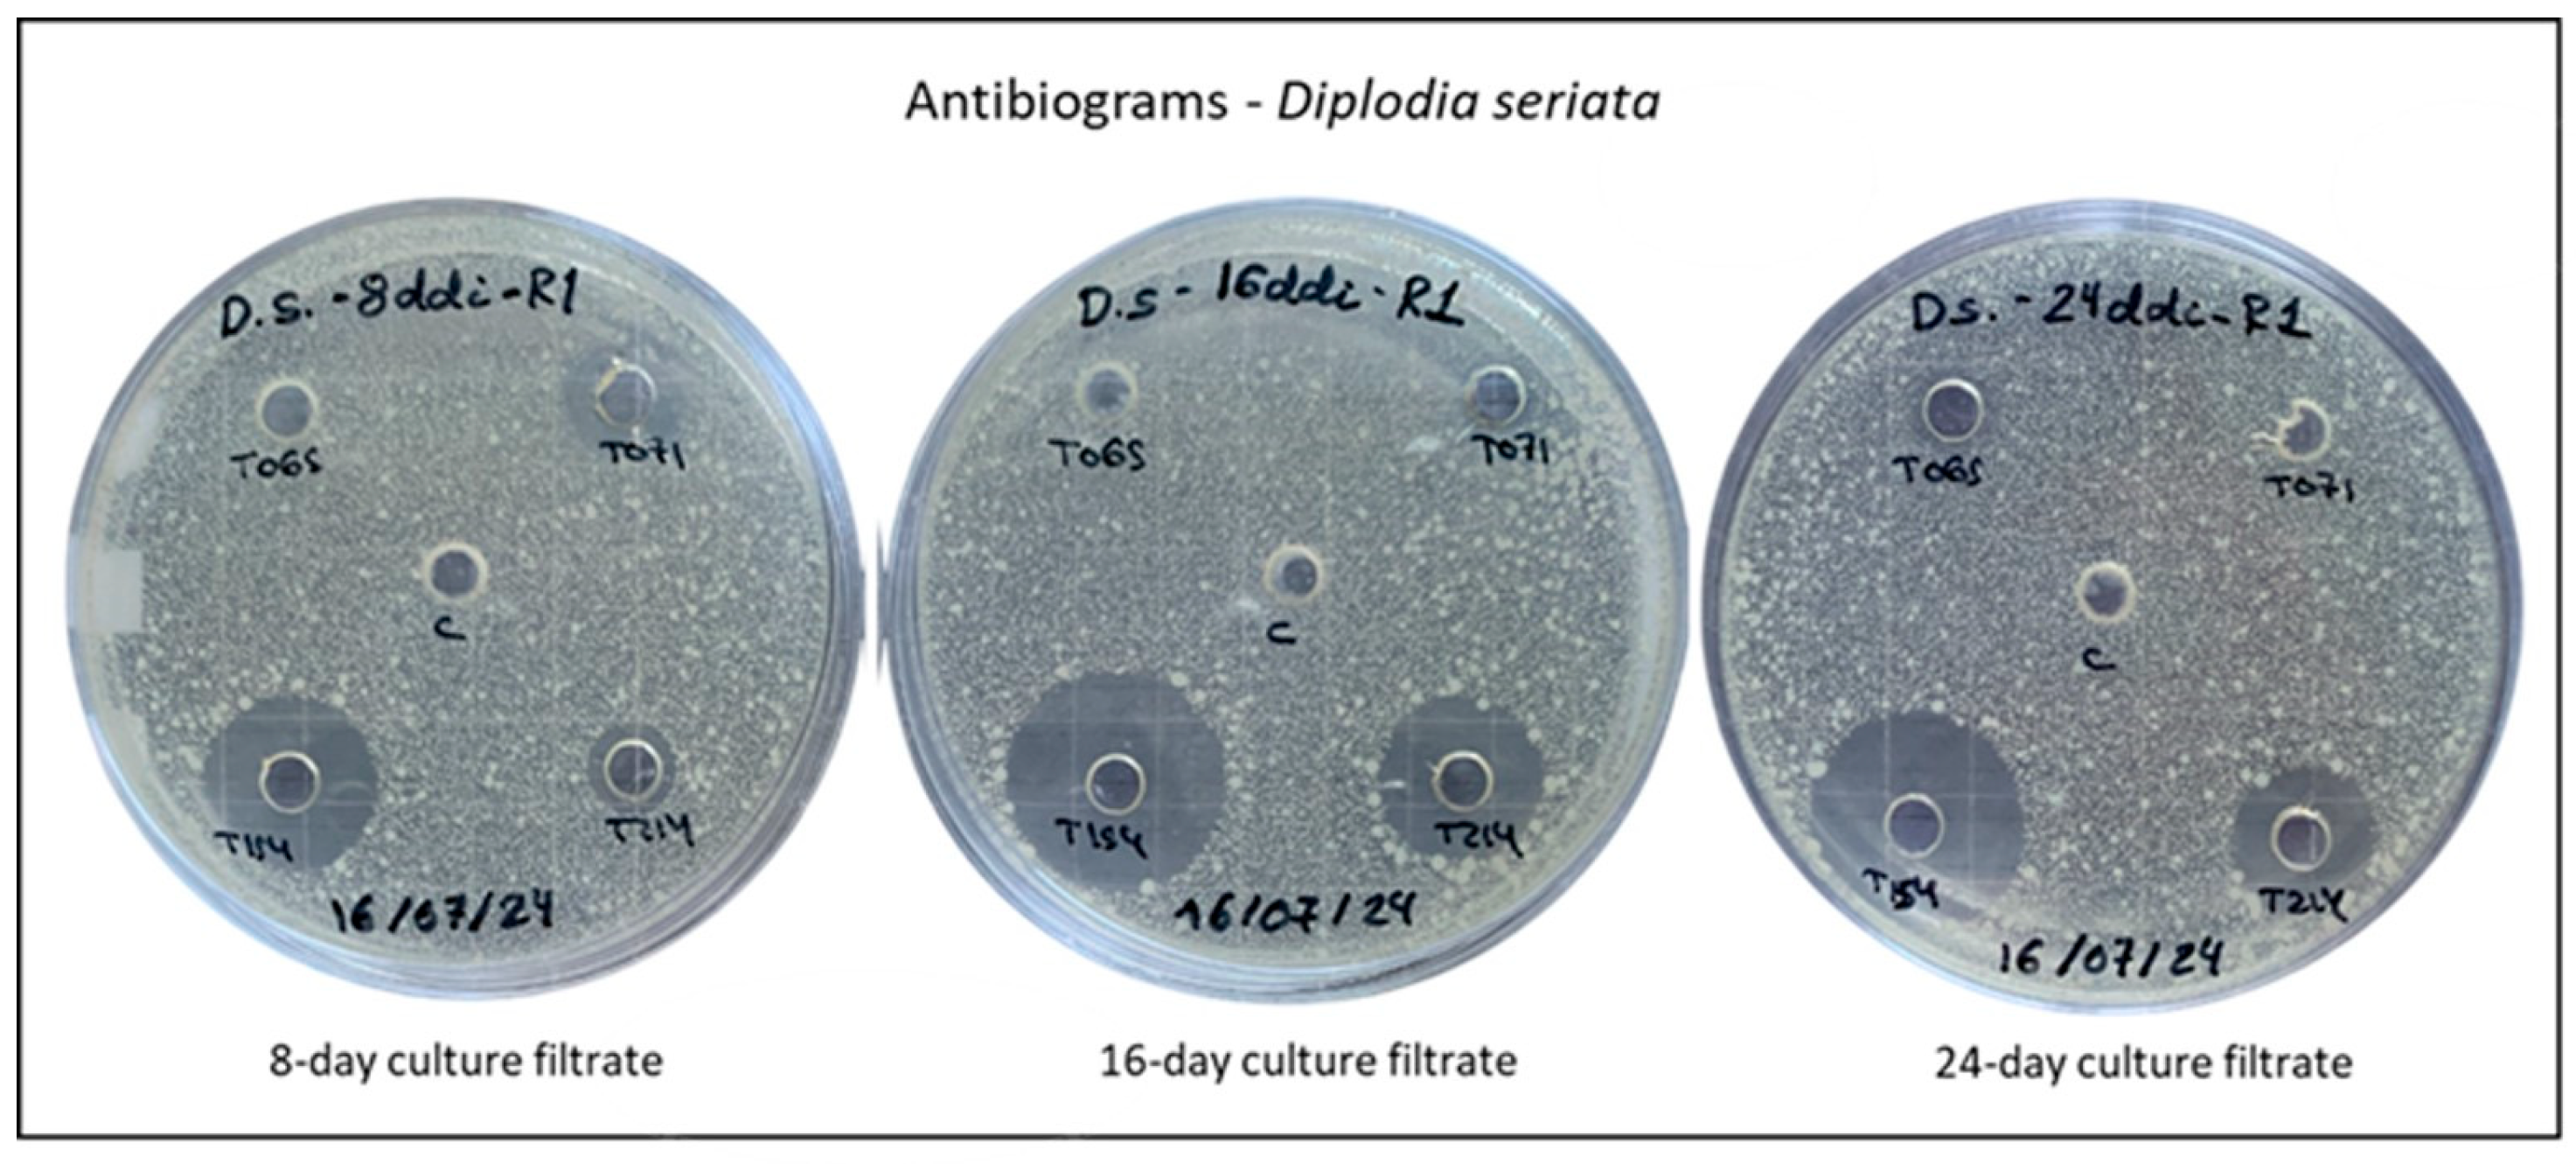
Agronomy 15 01901 g002 Agronomy 15 01901 g002

Biosolutions from Native Trichoderma Strains Against Grapevine Trunk Diseases
Abstract
1. Introduction
2. Materials and Methods
2.1. Fungal Strains
2.2. Culture Filtrates from Trichoderma
2.2.1. Fungal Culture Preparation
2.2.2. Filtrate Extraction
2.3. Experimental Design
2.4. Antifungal Assays
2.4.1. Antibiograms
2.4.2. Inhibition of Mycelial Growth
2.5. Statistical Analysis
3. Results
3.1. pH Evaluation
3.2. Antibiograms
3.3. Inhibition of Mycelial Growth
4. Discussion
5. Conclusions
Author Contributions
Funding
Data Availability Statement
Acknowledgments
Conflicts of Interest
References
- Skinner, M.; Parker, B.L.; Kim, J.S. Role of Entomopathogenic Fungi in Integrated Pest Management. In Integrated Pest Management: Current Concepts and Ecological Perspective; Elsevier Inc.: Amsterdam, The Netherlands, 2014; pp. 169–191. ISBN 9780124017092. [Google Scholar]
- Bamisile, B.S.; Akutse, K.S.; Siddiqui, J.A.; Xu, Y. Model Application of Entomopathogenic Fungi as Alternatives to Chemical Pesticides: Prospects, Challenges, and Insights for next-Generation Sustainable Agriculture. Front. Plant Sci. 2021, 12, 741804. [Google Scholar] [CrossRef]
- Fenibo, E.O.; Ijoma, G.N.; Matambo, T. Biopesticides in Sustainable Agriculture: A Critical Sustainable Development Driver Governed by Green Chemistry Principles. Front. Sustain. Food Syst. 2021, 5, 619058. [Google Scholar] [CrossRef]
- Nieto-Jacobo, M.F.; Steyaert, J.M.; Salazar-Badillo, F.B.; Vi Nguyen, D.; Rostás, M.; Braithwaite, M.; De Souza, J.T.; Jimenez-Bremont, J.F.; Ohkura, M.; Stewart, A.; et al. Environmental Growth Conditions of Trichoderma spp. Affects Indole Acetic Acid Derivatives, Volatile Organic Compounds, and Plant Growth Promotion. Front. Plant Sci. 2017, 8, 102. [Google Scholar] [CrossRef] [PubMed]
- Neme, A.; Leta, A.; Yones, A.M.; Tahir, M. Seedborne Mycoflora of Faba Bean (Vicia fabae L.) and Evaluation of Plant Extract and Trichoderma Species against Mycelium Growth of Selected Fungi. Heliyon 2023, 9, e17291. [Google Scholar] [CrossRef] [PubMed]
- Zanfaño, L.; Carro-Huerga, G.; Rodríguez-González, Á.; Mayo-Prieto, S.; Cardoza, R.E.; Gutiérrez, S.; Casquero, P.A. Trichoderma carraovejensis: A New Species from Vineyard Ecosystem with Biocontrol Abilities against Grapevine Trunk Disease Pathogens and Ecological Adaptation. Front. Plant Sci. 2024, 15, 1388841. [Google Scholar] [CrossRef]
- Vinale, F.; Marra, R.; Scala, F.; Ghisalberti, E.L.; Lorito, M.; Sivasithamparam, K. Major Secondary Metabolites Produced by Two Commercial Trichoderma Strains Active against Different Phytopathogens. Lett. Appl. Microbiol. 2006, 43, 143–148. [Google Scholar] [CrossRef]
- Harman, G.E.; Howell, C.R.; Viterbo, A.; Chet, I.; Lorito, M. Trichoderma Species—Opportunistic, Avirulent Plant Symbionts. Nat. Rev. Microbiol. 2004, 2, 43–56. [Google Scholar] [CrossRef]
- Ghasemi, S.; Safaie, N.; Shahbazi, S.; Shams-Bakhsh, M.; Askari, H. The Role of Cell Wall Degrading Enzymes in Antagonistic Traits of Trichoderma virens against Rhizoctonia solani. Iran. J. Biotechnol. 2020, 18, 18–28. [Google Scholar] [CrossRef]
- Rajesh, R.W.; Rahul, M.S.; Ambalal, N.S. Trichoderma: A Significant Fungus for Agriculture and Environment. Afr. J. Agric. Res. 2016, 11, 1952–1965. [Google Scholar] [CrossRef]
- Rauf, A.; Subhani, M.N.; Siddique, M.; Shahid, H.; Chattha, M.B.; Alrefaei, A.F.; Hasan Naqvi, S.A.; Ali, H.; Lucas, R.S. Cultivating a Greener Future: Exploiting Trichoderma Derived Secondary Metabolites for Fusarium Wilt Management in Peas. Heliyon 2024, 10, e29031. [Google Scholar] [CrossRef]
- Contreras-Cornejo, H.A.; Macías-Rodríguez, L.; del-Val, E.; Larsen, J. Ecological Functions of Trichoderma spp. and Their Secondary Metabolites in the Rhizosphere: Interactions with Plants. FEMS Microbiol. Ecol. 2016, 92, fiw036. [Google Scholar] [CrossRef] [PubMed]
- Mukherjee, P.K.; Horwitz, B.A.; Kenerley, C.M. Secondary Metabolism in Trichoderma—A Genomic Perspective. Microbiology 2012, 158, 35–45. [Google Scholar] [CrossRef]
- Vinale, F.; Sivasithamparam, K.; Ghisalberti, E.L.; Marra, R.; Barbetti, M.J.; Li, H.; Woo, S.L.; Lorito, M. A Novel Role for Trichoderma Secondary Metabolites in the Interactions with Plants. Physiol. Mol. Plant Pathol. 2008, 72, 80–86. [Google Scholar] [CrossRef]
- Woo, S.L.; Scala, F.; Ruocco, M.; Lorito, M. The Molecular Biology of the Interactions between Trichoderma spp., Phytopathogenic Fungi, and Plants. Phytopathology 2006, 96, 181–185. [Google Scholar] [CrossRef]
- Gruber, S.G.; Seidl-Seiboth, V. Self versus Non-Self: Fungal Cell Wall Degradation in Trichoderma. Microbiology 2012, 158, 26–34. [Google Scholar] [CrossRef] [PubMed]
- Mercer, C. Scientists Find New Clues to ‘Billion-Dollar’ Vine Diseases. Available online: https://www.decanter.com/wine-news/scientists-find-new-clues-to-billion-dollar-vine-diseases-484958/ (accessed on 12 February 2025).
- Sosnowski, M. Best Practice Management Guide. In Grapevine Trunk Disease; Wine Australia: Adelaide, SAU, Australia, 2019. [Google Scholar]
- Jaspers, M.; Sosnowski, M. Grapevine Trunk Diseases. In Eutypa & Botryosphaeria Dieback in Vineyards; Bragato Research Institute: Bienheim, New Zeland, 2021. [Google Scholar]
- Kenfaoui, J.; Radouane, N.; Mennani, M.; Tahiri, A.; El Ghadraoui, L.; Belabess, Z.; Fontaine, F.; El Hamss, H.; Amiri, S.; Lahlali, R.; et al. A Panoramic View on Grapevine Trunk Diseases Threats: Case of Eutypa Dieback, Botryosphaeria Dieback, and Esca Disease. J. Fungi 2022, 8, 595. [Google Scholar] [CrossRef]
- Travadon, R.; Lawrence, D.P.; Moyer, M.M.; Fujiyoshi, P.T.; Baumgartner, K. Fungal Species Associated with Grapevine Trunk Diseases in Washington Wine Grapes and California Table Grapes, with Novelties in the Genera Cadophora, Cytospora, and Sporocadus. Front. Fungal Biol. 2022, 3, 1018140. [Google Scholar] [CrossRef] [PubMed]
- Khan, R.A.A.; Najeeb, S.; Hussain, S.; Xie, B.; Li, Y. Bioactive Secondary Metabolites from Trichoderma spp. against Phytopathogenic Fungi. Microorganisms 2020, 8, 817. [Google Scholar] [CrossRef]
- Mutawila, C.; Vinale, F.; Halleen, F.; Lorito, M.; Mostert, L. Isolation, Production and in Vitro Effects of the Major Secondary Metabolite Produced by Trichoderma Species Used for the Control of Grapevine Trunk Diseases. Plant Pathol. 2016, 65, 104–113. [Google Scholar] [CrossRef]
- Pascale, A.; Vinale, F.; Manganiello, G.; Nigro, M.; Lanzuise, S.; Ruocco, M.; Marra, R.; Lombardi, N.; Woo, S.L.; Lorito, M. Trichoderma and Its Secondary Metabolites Improve Yield and Quality of Grapes. Crop Prot. 2017, 92, 176–181. [Google Scholar] [CrossRef]
- Mesguida, O.; Haidar, R.; Yacoub, A.; Dreux-Zigha, A.; Berthon, J.Y.; Guyoneaud, R.; Attard, E.; Rey, P. Microbial Biological Control of Fungi Associated with Grapevine Trunk Diseases: A Review of Strain Diversity, Modes of Action, and Advantages and Limits of Current Strategies. J. Fungi 2023, 9, 638. [Google Scholar] [CrossRef] [PubMed]
- Jangid, P.K.; Mathur, P.N.; Mathur, K. Role of Chitinase and β-1,3 Glucanase Elicitation in the Trichoderma harzianum Induced Systemic Resistance in Capsicum. Indian Phytopath 2004, 57, 217–221. [Google Scholar]
- Mutawila, C.; Stander, C.; Halleen, F.; Vivier, M.A.; Mostert, L. Response of Vitis vinifera Cell Cultures to Eutypa lata and Trichoderma atroviride Culture Filtrates: Expression of Defence-Related Genes and Phenotypes. Protoplasma 2017, 254, 863–879. [Google Scholar] [CrossRef]
- Stempien, E.; Pierron, R.J.G.; Adendorff, I.; Van Jaarsveld, W.J.; Halleen, F.; Mostert, L. Host Defence Activation and Root Colonization of Grapevine Rootstocks by the Biological Control Fungus Trichoderma atroviride. Phytopathol. Mediterr. 2020, 59, 615–626. [Google Scholar] [CrossRef]
- Carro-Huerga, G.; Mayo-Prieto, S.; Rodríguez-González, Á.; Álvarez-García, S.; Gutiérrez, S.; Casquero, P.A. The Influence of Temperature on the Growth, Sporulation, Colonization, and Survival of Trichoderma spp. in Grapevine Pruning Wounds. Agronomy 2021, 11, 1771. [Google Scholar] [CrossRef]
- Rodríguez-González, A.; Carro-Huerga, G.; Mayo-Prieto, S.; Lorenzana, A.; Gutiérrez, S.; Peláez, H.J.; Casquero, P.A. Investigations of Trichoderma spp. and Beauveria bassiana as Biological Control Agent for Xylotrechus arvicola, a Major Insect Pest in Spanish Vineyards. J. Econ. Entomol. 2018, 111, 2585–2591. [Google Scholar] [CrossRef] [PubMed]
- Gramaje, D.; Úrbez-Torres, J.R.; Sosnowski, M.R. Managing Grapevine Trunk Diseases with Respect to Etiology and Epidemiology: Current Strategies and Future Prospects. Plant Dis. 2018, 102, 12–39. [Google Scholar] [CrossRef]
- Martín, L.; Martín, M.T. Characterization of Fungicide Resistant Isolates of Phaeoacremonium aleophilum Infecting Grapevines in Spain. Crop Prot. 2013, 52, 141–150. [Google Scholar] [CrossRef]
- Martín, M.T.; Cobos, R.; Martín, L.; López-Enríquez, L. Real-Time PCR Detection of Phaeomoniella chlamydospora and Phaeoacremonium aleophilum. Appl. Environ. Microbiol. 2012, 78, 3985–3991. [Google Scholar] [CrossRef]
- Malmierca, M.G.; Cardoza, R.E.; Alexander, N.J.; McCormick, S.P.; Hermosa, R.; Monte, E.; Gutiérrez, S. Involvement of Trichoderma Trichothecenes in the Biocontrol Activity and Induction of Plant Defense-Related Genes. Appl. Env. Microbiol. 2012, 78, 4856–4868. [Google Scholar] [CrossRef]
- Carro-Huerga, G.; Mayo-Prieto, S.; Rodríguez-González, Á.; Cardoza, R.E.; Gutiérrez, S.; Casquero, P.A. Vineyard Management and Physicochemical Parameters of Soil Affect Native Trichoderma Populations, Sources of Biocontrol Agents against Phaeoacremonium minimum. Plants 2023, 12, 887. [Google Scholar] [CrossRef] [PubMed]
- Chaverri, P.; Branco-Rocha, F.; Jaklitsch, W.; Gazis, R.; Degenkolb, T.; Samuels, G.J. Systematics of the Trichoderma harzianum Species Complex and the Re-Identification of Commercial Biocontrol Strains. Mycologia 2015, 107, 558–590. [Google Scholar] [CrossRef] [PubMed]
- Fanelli, F.; Liuzzi, V.C.; Logrieco, A.F.; Altomare, C. Genomic Characterization of Trichoderma atrobrunneum (T. harzianum Species Complex) ITEM 908: Insight into the Genetic Endowment of a Multi-Target Biocontrol Strain. BMC Genom. 2018, 19, 662. [Google Scholar] [CrossRef] [PubMed]
- Ismaiel, A.; Jambhulkar, P.P.; Sinha, P.; Lakshman, D.K. Trichoderma: Harzianum Clade in Soils from Central and South America. J. Fungi 2024, 10, 813. [Google Scholar] [CrossRef]
- Benítez, T.; Rincón, A.M.; Limón, M.C.; Codón, A.C. Biocontrol Mechanism of Trichoderma Strains. Int. Microbiol. 2004, 7, 249–260. [Google Scholar]
- Maurya, M.K.; Srivastava, M. Harshita Effect of Various PH Levels on the Growth and Sporulation of Trichoderma viride Isolates and Assessing Their Antagonistic Activity against Soil-Borne Pathogens. J. Pure Appl. Microbiol. 2024, 18, 2516–2527. [Google Scholar] [CrossRef]
- Chalimah, N.; Soesanto, L.; Suharti, W.S. The Effect of Various PH Medium on the Secondary Metabollites Production from Trichoderma harzianum T10 to Control Damping off on Cucumber Seedlings. J. Trop. Hortic. 2020, 3, 65. [Google Scholar] [CrossRef]
- Trushina, N.; Levin, M.; Mukherjee, P.K.; Horwitz, B.A. PacC and PH-Dependent Transcriptome of the Mycotrophic Fungus Trichoderma virens. BMC Genom. 2013, 14, 138. [Google Scholar] [CrossRef]
- Balouiri, M.; Sadiki, M.; Ibnsouda, S.K. Methods for in Vitro Evaluating Antimicrobial Activity: A Review. J. Pharm. Anal. 2016, 6, 71–79. [Google Scholar] [CrossRef] [PubMed]
- Sedjati, S.; Ambariyanto, A.; Trianto, A.; Ridlo, A.; Supriyantini, E.; Sabdono, A.; Radjasa, O.K.; Firmansyah, T. Antibacterial Activity of the Fungal Metabolite Trichoderma longibrachiatum against Multidrug-Resistant Klebsiella pneumoniae and Methicillin-Resistant Staphylococcus aureus. Jordan. J. Biol. Sci. 2022, 15, 107–113. [Google Scholar] [CrossRef]
- Carro-Huerga, G.; Compant, S.; Gorfer, M.; Cardoza, R.E.; Schmoll, M.; Gutiérrez, S.; Casquero, P.A. Colonization of Vitis vinifera L. by the Endophyte Trichoderma sp. Strain T154: Biocontrol Activity against Phaeoacremonium minimum. Front. Plant Sci. 2020, 11, 1170. [Google Scholar] [CrossRef]
- Pertot, I.; Prodorutti, D.; Colombini, A.; Pasini, L. Trichoderma atroviride SC1 Prevents Phaeomoniella chlamydospora and Phaeoacremonium aleophilum Infection of Grapevine Plants during the Grafting Process in Nurseries. BioControl 2016, 61, 257–267. [Google Scholar] [CrossRef]
- Di Marco, S.; Metruccio, E.G.; Moretti, S.; Nocentini, M.; Carella, G.; Pacetti, A.; Battiston, E.; Osti, F.; Mugnai, L. Activity of Trichoderma asperellum Strain ICC 012 and Trichoderma gamsii Strain ICC 080 toward Diseases of Esca Complex and Associated Pathogens. Front. Microbiol. 2022, 12, 813410. [Google Scholar] [CrossRef] [PubMed]
- Vinale, F.; Strakowska, J.; Mazzei, P.; Piccolo, A.; Marra, R.; Lombardi, N.; Manganiello, G.; Pascale, A.; Woo, S.L.; Lorito, M. Cremenolide, a New Antifungal, 10-Member Lactone from Trichoderma cremeum with Plant Growth Promotion Activity. Nat. Prod. Res. 2016, 30, 2575–2581. [Google Scholar] [CrossRef] [PubMed]
- Thrane, C.; Funck Jensen, D.; Tronsmo, A. Substrate Colonization, Strain Competition, Enzyme Production in Vitro, and Biocontrol of Pythium ultimum by Trichoderma spp. Isolates P1 and T3. Eur. J. Plant Pathol. 2000, 106, 215–225. [Google Scholar] [CrossRef]
- Bigot, G.; Sivilotti, P.; Stecchina, M.; Lujan, C.; Freccero, A.; Mosetti, D. Long-Term Effects of Trichoderma asperellum and Trichoderma gamsii on the Prevention of Esca in Different Vineyards of Northeastern Italy. Crop Prot. 2020, 137, 10526. [Google Scholar] [CrossRef]
- Vinale, F.; Nicoletti, R.; Borrelli, F.; Mangoni, A.; Parisi, O.A.; Marra, R.; Lombardi, N.; Lacatena, F.; Grauso, L.; Finizio, S.; et al. Co-Culture of Plant Beneficial Microbes as Source of Bioactive Metabolites. Sci. Rep. 2017, 7, 14330. [Google Scholar] [CrossRef]
- del Carmen H. Rodríguez, M.; Evans, H.C.; de Abreu, L.M.; de Macedo, D.M.; Ndacnou, M.K.; Bekele, K.B.; Barreto, R.W. New Species and Records of Trichoderma Isolated as Mycoparasites and Endophytes from Cultivated and Wild Coffee in Africa. Sci. Rep. 2021, 11, 5671. [Google Scholar] [CrossRef]
- Nascimento Brito, V.; Lana Alves, J.; Sírio Araújo, K.; de Souza Leite, T.; Borges de Queiroz, C.; Liparini Pereira, O.; de Queiroz, M.V. Endophytic Trichoderma Species from Rubber Trees Native to the Brazilian Amazon, Including Four New Species. Front. Microbiol. 2023, 14, 1095199. [Google Scholar] [CrossRef] [PubMed]

| Isolate | Trichoderma spp. | Origin | References |
|---|---|---|---|
| T065 | Trichoderma gamsii | Soil of vineyard, PDO León, Spain | [30] |
| T071 | Trichoderma gamsii | Soil of vineyard, PDO León, Spain | [31] |
| T154 | Trichoderma carraovejensis | Wood of Vitis vinifera cv. Tempranillo, Spain | [6] |
| T214 | Trichoderma harzianum | Wood of Vitis vinifera cv. Verdejo, Spain | [30] |
Disclaimer/Publisher’s Note: The statements, opinions and data contained in all publications are solely those of the individual author(s) and contributor(s) and not of MDPI and/or the editor(s). MDPI and/or the editor(s) disclaim responsibility for any injury to people or property resulting from any ideas, methods, instructions or products referred to in the content. |
© 2025 by the authors. Licensee MDPI, Basel, Switzerland. This article is an open access article distributed under the terms and conditions of the Creative Commons Attribution (CC BY) license (https://creativecommons.org/licenses/by/4.0/).
Share and Cite
Zanfaño, L.; Carro-Huerga, G.; Rodríguez-González, Á.; Ramírez-Lozano, D.; Mayo-Prieto, S.; Gutiérrez, S.; Casquero, P.A. Biosolutions from Native Trichoderma Strains Against Grapevine Trunk Diseases. Agronomy 2025, 15, 1901. https://doi.org/10.3390/agronomy15081901
Zanfaño L, Carro-Huerga G, Rodríguez-González Á, Ramírez-Lozano D, Mayo-Prieto S, Gutiérrez S, Casquero PA. Biosolutions from Native Trichoderma Strains Against Grapevine Trunk Diseases. Agronomy. 2025; 15(8):1901. https://doi.org/10.3390/agronomy15081901
Chicago/Turabian StyleZanfaño, Laura, Guzmán Carro-Huerga, Álvaro Rodríguez-González, Daniela Ramírez-Lozano, Sara Mayo-Prieto, Santiago Gutiérrez, and Pedro A. Casquero. 2025. "Biosolutions from Native Trichoderma Strains Against Grapevine Trunk Diseases" Agronomy 15, no. 8: 1901. https://doi.org/10.3390/agronomy15081901
APA StyleZanfaño, L., Carro-Huerga, G., Rodríguez-González, Á., Ramírez-Lozano, D., Mayo-Prieto, S., Gutiérrez, S., & Casquero, P. A. (2025). Biosolutions from Native Trichoderma Strains Against Grapevine Trunk Diseases. Agronomy, 15(8), 1901. https://doi.org/10.3390/agronomy15081901

